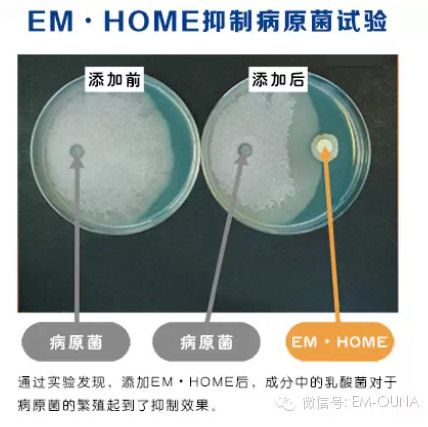
EM����������ϵ�С���EM.home�������¾���������������

咨询热线:029-89298328
 公司微信
公司微信 新浪博客
新浪博客 网易博客
网易博客EM环境改良剂系列――EM.home空气清新净化剂火热招商中
来源:西部果友联盟 | 作者:西部果友联盟 | 时间:2015-03-28 16:49

关于EM.home
EM.home是将存在于自然界中的有益微生物,包括乳酸菌、酵母菌、光合菌等进行混合培养,是对人体安全的微生物集合体。也就是说,它们并不像消毒剂等化学制剂一样对有益菌和有害菌进行一网打尽,而是通过有益菌的集合、提高有益菌的密度来防止和控制有害菌的滋生和繁殖。而且,利用微生物自身的净化力可以净化环境、控制恶臭和异味的产生。
作为环境的解决手段,EM技术目前已经在世界140几个国际和地区得到广泛推广和使用。
EM.home的作用效果
1、用于家庭
EM.home是纯微生物制剂,无二次污染。能有效分解污垢(有机物)及臭味的产生,并能抑制有害杂菌的繁殖。将EM.home稀释液喷洒在厨房、卫生间、下水道、空调、生活垃圾等易产生异味的地方,有效抑制杂菌及臭味的产生。
EM.home用于蔬菜卫生、保鲜,可以有效抑制大肠杆菌和其他病原菌的增殖。
2、用于宠物饲养
将EM.home按照一定比例稀释喷洒在狗、猫身上,可减少宠物异味,抑制螨虫、病原菌滋生。
3、用于车内异味去除
停车后将EM.home按照一定比例稀释喷洒在车内,并关闭门窗,可去除烟味、抑制车内有害气味的产生。
|
- 上一篇:甘肃静宁格瑞合作社领跑果农致富路
- 下一篇:EM菌在阳台盆栽蔬菜上的使用技术
